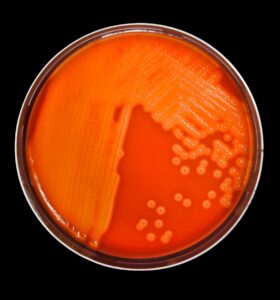

International Group B Strep Awareness Month: Understanding a Silent Threat to Newborns
July marks International Group B Strep Awareness Month, a time dedicated to educating the public about a common bacterium that can have serious implications for newborns. Group B Streptococcus (GBS), also known as Streptococcus agalactiae, is a type of bacteria that naturally resides in the intestines and genital tracts of many healthy adults. While generally harmless in adults, GBS can pose a significant risk to newborns if transmitted during pregnancy or childbirth.
What is Group B Strep?
Group B Streptococcus is a gram-positive bacterium that colonizes the gastrointestinal and genitourinary tracts of up to 30% of healthy adults. In most cases, these individuals are asymptomatic carriers, unaware of the bacteria’s presence. However, GBS can become problematic during pregnancy and in the immediate postpartum period, as it can be passed from mother to baby during delivery.
GBS is a leading cause of sepsis and meningitis in newborns, making it a critical concern in obstetrics and neonatology. The bacteria can cause two types of infections in newborns: early-onset disease (occurring within the first week of life) and late-onset disease (occurring between one week and three months of age).
Signs and Symptoms of Group B Strep in Newborns
Early-onset GBS disease typically manifests within the first 24 to 48 hours after birth. Symptoms can include:
- Fever or abnormally low body temperature
- Difficulty feeding
- Irritability or lethargy
- Difficulty breathing or rapid breathing
- Blue-ish skin color (cyanosis)
- Seizures
Late-onset GBS disease can present with similar symptoms but may also include:
- Stiff neck or body
- Bulging fontanelle (soft spot on the baby’s head)
- Poor muscle tone
- Inconsolable crying
It’s crucial for parents and caregivers to be aware of these signs and seek immediate medical attention if they observe any of these symptoms in a newborn.
Testing for Group B Strep
Given the potential severity of GBS infections in newborns, routine screening has become standard practice in many countries. In the United States, the Centers for Disease Control and Prevention (CDC) recommends that all pregnant women be screened for GBS between 36 and 37 weeks of gestation.
The screening process involves a simple and painless swab test of the vagina and rectum. The samples are then cultured in a laboratory to detect the presence of GBS. Results are typically available within 24 to 48 hours.
It’s important to note that GBS colonization can be transient. A negative test result earlier in pregnancy does not guarantee that a woman will remain GBS-negative at the time of delivery. Conversely, a positive result doesn’t mean that the baby will definitely become infected. The test helps identify women who may benefit from preventive antibiotics during labor to reduce the risk of transmission to the baby.
Complications of Group B Strep
While many babies exposed to GBS during birth do not develop an infection, those who do can face serious complications. These may include:
- Sepsis: A life-threatening condition where the body’s response to infection causes widespread inflammation and organ failure.
- Pneumonia: Infection of the lungs that can lead to breathing difficulties and respiratory failure.
- Meningitis: Inflammation of the membranes surrounding the brain and spinal cord, which can result in long-term neurological problems or death.
- Cerebral palsy: A group of disorders affecting movement and muscle tone or posture, which can be a consequence of brain damage from severe GBS infection.
- Hearing or vision loss: Sensory impairments can occur as a result of severe infection or its treatment.
- Learning disabilities: Some survivors of GBS meningitis may experience cognitive challenges later in life.
- Death: In severe cases, particularly if left untreated, GBS infection can be fatal.
Prevention and Treatment
The primary strategy for preventing GBS disease in newborns is intrapartum antibiotic prophylaxis (IAP). Women who test positive for GBS are typically given intravenous antibiotics during labor to reduce the risk of transmitting the bacteria to the baby. This approach has significantly decreased the incidence of early-onset GBS disease since its implementation.
For babies who develop GBS infection, prompt treatment with antibiotics is crucial. Early diagnosis and intervention can dramatically improve outcomes and reduce the risk of long-term complications.
Conclusion
International Group B Strep Awareness Month serves as a vital reminder of the importance of prenatal care and screening. By raising awareness about GBS, we can empower expectant parents with the knowledge to advocate for appropriate testing and treatment, ultimately protecting more newborns from this potentially devastating infection.
As research continues, there is hope for even more effective prevention strategies in the future, including the development of a maternal GBS vaccine. Until then, education, screening, and prompt treatment remain our best defenses against Group B Streptococcus and its impact on newborn health.

Nancy L. Kimmel obtained her PhD in Environmental Engineering in 2002, then went on to teach Physics and Mechanical Engineering at Lawrence Technological University, Henry Ford College and Oakland University. She obtained her Associate in Nursing from Henry Ford College and then went on to earn her Master Degree as a Family Nurse Practitioner and became Board Certified working as a licensed FNP in the State of Michigan. She then went on to Medical School where she is now in her 3rd year, and is also in the process of obtaining her Doctorate in Nursing Practice through Chamberlin University. She has authored the NET Study Guide, as well a several books on subjects of Math, ECG/EKG and Phlebotomy. She holds a patent on an Air Filter through the U.S. Patent Office.
313-826-2381


